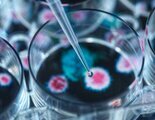
Alerta en Reino Unido por la llegada de la letal peste porcina africana

Archivo 05 Agosto 2024

Un estudio revela con qué famosos se tomarían una cerveza en cada comunidad
Una encuesta revela resultados diferentes por territorios, incluyendo políticos, cantantes o deportistas.

Una turista británica estalla con lo que se encuentra al visitar un McDonald's en España
Una turista revela las diferencias entre los establecimientos de cada país y los productos que le han llamado la atención.

Aclaran la verdadera causa tras la muerte del torero Pepe Luis Vázquez
El torero falleció a los 67 años dentro de su finca sevillana de Carmona.

La juguetería Poly cierra todas sus tiendas en España
La empresa ha aprobado un ERE para liquidar todos sus contratos laborales, en total 169 empleaos.

Muere un hombre en Girona tras hacer un ritual con gallinas decapitadas
El caso se encuentra actualmente bajo investigación tras el sorprendente hallazgo de los investigadores.
Alerta en Reino Unido por la llegada de la letal peste porcina africana
Las autoridades han intensificado los controles y advierten de las consecuencias de la epidemia.

El comportamiento de unos padres mientras compite su hija en los JJOO se hace viral en TikTok
La cuenta oficial de los Juegos Olímpicos ha publicado en la red social un fragmento de uno de los mejores momentos en Olimpiadas de Londres de 2012.

La triatleta belga Claire Michael, hospitalizada después de nadar en el río Sena
Está infectada por el E.Coli, bacteria por la que ya se han suspendido entrenamientos y pruebas en los Juegos Olímpicos.

La Bolsa de Japón se hunde un 12,40% en su peor sesión desde 1987 por miedo a una recesión global
El Ibex 35 cae casi un 3% en la apertura tras el hundimiento de las bolsas asiáticas. Otros mercados asiáticos también van a mostrar un descenso.

Encuentran muerto a Alejandro Martín, el peluquero desaparecido en El Bierzo
El joven empresario llevaba desaparecido desde el pasado 27 de julio.

Esta es la mejor empanada de atún del supermercado, según la OCU
La Organización de Consumidores y Usuarios (OCU) analiza las empanadas vendidas en supermercados de España.

Desokupa formará en defensa personal a 30.000 agentes de Policía tras un acuerdo con el SUP
Interior ha aclarado que los cursos no son homologables ni cuentan con respaldo por parte de la Dirección General de Policía.
